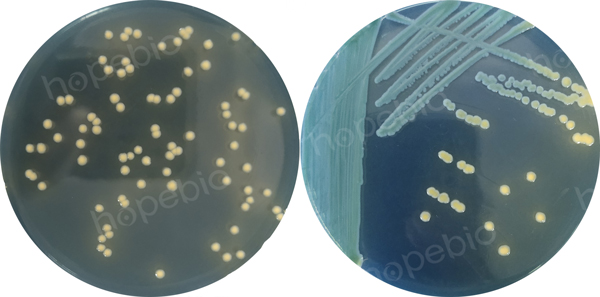

海博微信公众号
海博微信公众号
 海博天猫旗舰店
海博天猫旗舰店


 海博微信公众号
海博微信公众号
 海博天猫旗舰店
海博天猫旗舰店




一、阴沟肠杆菌简介
阴沟肠杆菌(Enterobacter cloacae)是肠杆菌科肠杆菌属的模式菌,广泛分布于自然界,普遍存在于人和动物的肠道中,是医院内感染和机会感染的常见细菌,也能引起食源性疾病,因此常常被当作条件致病菌的代表。
奶粉中阴沟肠杆菌的污染一直受到人们的关注,2004年4月,联合国粮农组织和世界卫生组织的专家在评估婴儿配方奶粉安全性时,认为阴沟肠杆菌在引起新生儿致病方面的重要性正在增长,并且作为肠杆菌属的代表(在婴儿奶粉中以低浓度出现的)是潜在的婴儿奶粉病原菌,在进行婴儿配方奶粉中致病菌的风险分析时,将阴沟肠杆菌列为“B”类危险性生物因子。
据调查报告表明奶粉中污染阴沟肠杆菌的含量一般较低,为此本方法定量检测取样量确定为333 g,以尽可能检测出样品中含量少的目标菌。
二、参考标准
《SN/T 2552.7-2010 乳与乳制品卫生微生物学检验方法 第7部分:阴沟肠杆菌检验》
三、阴沟肠杆菌检验方法
3.1 方法提要
奶粉中阴沟肠杆菌的分离与计数方法是应用微生物检验的增菌培养、分离、生化鉴定等方法对奶粉中可能存在的阴沟肠杆菌进行定性和定量的检验。
3.2 检验程序
阴沟肠杆菌的检验程序见图1。

图1 阴沟肠杆菌检验程序
四、检测步骤及结果判断
4.1阴沟肠杆菌定量检验(MPN法)
4.1.1 定量检验是应用“三管”增菌法,检验和定量样品中极少量的阴沟肠杆菌。检验需333g样品。取样见SN/T 2552.1。
4.1.2 取样前消毒样品包装的开启处和取样勺,无菌称取样品100g、10g和1g各三份分别加入2L、250mL和125mL样品稀释瓶中,在各样品稀释瓶中分别加入900mL、90mL、9mL预热到45℃的灭菌蒸馏水(1:10稀释),振摇使样品充分混匀,36℃±1℃培养18h~22h。
4.1.3 分别移取培养18h~22h的悬液各10mL加入90mLEE肉汤中,36℃±1℃培养18h~22h。
肠道菌增菌肉汤(EE)检验原理:蛋白胨为微生物生长提供蛋白质、维生素和氨基酸;葡萄糖提供碳源;磷酸氢二钠和磷酸二氢钾为缓冲剂;牛胆盐和煌绿为选择性抑菌剂,可抑制非肠杆菌科细菌的生长。
肠道菌增菌肉汤(EE)用法:称取本品45g,加热搅拌溶解于1000mL蒸馏水中,分装三角瓶,每瓶90mL,100℃加热30分钟,迅速在流动的冷水中冷却,无需高压灭菌。培养结果如图2所示:

图2 阴沟肠杆菌在EE肉汤中的培养结果
4.1.4 轻轻混匀增菌液,用下列方法进行平板接种:
直接涂布法:每份增菌液取0.2mL加到2个阴沟肠杆菌分离琼脂平板(ECIA),每个平板0.1mL,用无菌玻璃涂布棒涂布(如果预计奶粉中含有大量的细菌,应使用灭菌的EE肉汤将增菌液稀释10-4~10-6后涂布)。
直接划线法:每份增菌液用3mm接种环(10μL)分别接种2个阴沟肠杆菌分离琼脂平板,三区法或四区法划线,以得到单个菌落。将平板倒置于36℃±1℃,培养18h~22h。
阴沟肠杆菌分离琼脂(ECIA)检验原理:特殊蛋白胨为微生物的生长提供氮源、维生素和生长因子;氯化钠维持均衡的渗透压;3号胆盐和结晶紫为抑菌剂;溴麝香草酚蓝为pH指示剂,变色范围为pH值6.0~7.6,酸性呈黄色,碱性呈蓝色;棉子糖为可发酵糖类,发酵糖产酸的菌落呈黄色;琼脂是培养基的凝固剂。
阴沟肠杆菌分离琼脂(ECIA)用法:称取本品49.6g,加热煮沸溶解于1000mL蒸馏水中,冷却至50℃左右时,倾入无菌平皿,备用。无需高压灭菌。培养结果如图3所示:
图3 阴沟肠杆菌在ECIA平板上的培养结果
4.1.5 观察平板上阴沟肠杆菌的典型形态
在阴沟肠杆菌分离琼脂平板上:黄色菌落,圆形,凸起,直径2mm~3mm。
4.1.6 从阴沟肠杆菌分离琼脂平板上挑取5个可疑菌落,分别进行初步生化试验:赖氨酸脱羧酶、鸟氨酸脱羧酶、精氨酸双水解酶试验。初步生化试验结果如图4:

图4 初步生化实验结果
4.1.7 对赖氨酸脱羧酶阴性、鸟氨酸脱羧酶阳性、精氨酸双水解酶阳性的可疑菌落,进行革兰氏染色,氧化酶试验。革兰氏染色阴性,氧化酶试验阴性按表1进行生化试验。革兰氏染色结果如图5,氧化酶试验结果如图5:

图5 阴沟肠杆菌革兰氏染色结果,阴沟肠杆菌氧化酶实验结果
4.1.8 肠杆菌属细菌生化特征见表1。生化试验结果如图6所示。
表1 肠杆菌属细菌生化特征
|
试验 |
生化特征 |
|||||
|
阴沟肠杆菌 E.cloacae |
阪崎肠杆菌 E.sakazakii |
产气肠杆菌 E.aerogenes |
聚团肠杆菌 E.agglomerans |
格高菲肠杆菌 E.gergoviae |
||
|
赖氨酸脱酸酶 |
- |
- |
+ |
- |
+ |
|
|
精氨酸双水解酶 |
+ |
+ |
- |
- |
- |
|
|
鸟氨酸脱酸酶 |
+ |
+ |
+ |
- |
+ |
|
|
发酵 |
KCN生长 |
+ |
+ |
+ |
v |
- |
|
蔗糖 |
+ |
+ |
+ |
(+) |
+ |
|
|
卫矛醇 |
(-) |
- |
- |
(-) |
- |
|
|
核糖醇 |
(-) |
- |
+ |
- |
- |
|
|
棉子糖 |
+ |
+ |
+ |
v |
+ |
|
|
D-山梨醇 |
+ |
- |
+ |
v |
- |
|
|
α-甲基-D-葡萄糖苷 |
(+) |
+ |
- |
- |
- |
|
|
D-阿拉伯糖 |
(-) |
- |
+ |
- |
+ |
|
|
黄色素 |
- |
+ |
- |
(+) |
- |
|
|
注:+:90%~100%阳性;(+):75%~89%阳性;v:25%~74%阳性;(-):10%~24%阳性;-:0%~9%阳性 |
||||||

图6 确证生化试验结果
4.1.9 计算MPN值,根据每一稀释度检出的阴沟肠杆菌的结果查MPN表(见表2),计算并报告每100g样品中的阴沟肠杆菌的最近似值。
4.2阴沟肠杆菌定性检验
4.2.1 检验样品中是否有阴沟肠杆菌,检验需100g样品。
4.2.2 取样前消毒样品包装的开启处和取样勺,无菌称取样品100g至2L的样品稀释瓶中,加入900mL预热到45℃的灭菌蒸馏水,或将样品直接称量到装有9倍预热到45℃的灭菌蒸馏水的样品稀释瓶中,振摇使样品充分混匀,36℃±1℃培养18h~22h。
4.2.3 移取培养18h~22h的悬液各10mL加入90mL EE肉汤中,36℃±1℃培养18h~22h。
4.2.4 操作同4.1.4~4.1.8。
4.2.5 根据检验结果,报告每100 g样品中是否检出阴沟肠杆菌。
表2 最可能数(MPN)表(95%置信区间)
使用三管法,接种量分别为10.0g,1.0g和0.1g。
|
阳性管数 |
MPN /100g |
可信限 |
阳性管数 |
MPN /100g |
可信限 |
||||||
|
10 |
1 |
0.1 |
低 |
高 |
10 |
1 |
0.1 |
低 |
高 |
||
|
0 |
0 |
0 |
<3.0 |
- |
9.5 |
2 |
2 |
0 |
21 |
4.5 |
42 |
|
0 |
0 |
1 |
3.0 |
0.15 |
9.6 |
2 |
2 |
1 |
28 |
8.7 |
94 |
|
0 |
1 |
0 |
3.0 |
0.15 |
11 |
2 |
2 |
2 |
35 |
8.7 |
94 |
|
0 |
1 |
1 |
6.1 |
1.2 |
18 |
2 |
3 |
0 |
29 |
8.7 |
94 |
|
0 |
2 |
0 |
6.2 |
1.2 |
18 |
2 |
3 |
1 |
36 |
8.7 |
94 |
|
0 |
3 |
0 |
9.4 |
3.6 |
38 |
3 |
0 |
0 |
23 |
4.6 |
94 |
|
1 |
0 |
0 |
3.6 |
0.17 |
18 |
3 |
0 |
1 |
38 |
8.7 |
110 |
|
1 |
0 |
1 |
7.2 |
1.3 |
18 |
3 |
0 |
2 |
64 |
17 |
180 |
|
1 |
0 |
2 |
11 |
3.6 |
38 |
3 |
1 |
0 |
43 |
9 |
180 |
|
1 |
1 |
0 |
7.4 |
1.3 |
20 |
3 |
1 |
1 |
75 |
17 |
200 |
|
1 |
1 |
1 |
11 |
3.6 |
38 |
3 |
1 |
2 |
120 |
37 |
420 |
|
1 |
2 |
0 |
11 |
3.6 |
42 |
3 |
1 |
3 |
160 |
40 |
420 |
|
1 |
2 |
1 |
15 |
4.5 |
42 |
3 |
2 |
0 |
93 |
18 |
420 |
|
1 |
3 |
0 |
16 |
4.5 |
42 |
3 |
2 |
1 |
150 |
37 |
420 |
|
2 |
0 |
0 |
9.2 |
4.4 |
38 |
3 |
2 |
2 |
210 |
40 |
430 |
|
2 |
0 |
1 |
14 |
3.6 |
42 |
3 |
2 |
3 |
290 |
90 |
1000 |
|
2 |
0 |
2 |
20 |
4.5 |
42 |
3 |
3 |
0 |
240 |
42 |
1000 |
|
2 |
1 |
0 |
15 |
3.7 |
42 |
3 |
3 |
1 |
460 |
90 |
2000 |
|
2 |
1 |
1 |
20 |
4.5 |
42 |
3 |
3 |
2 |
1100 |
180 |
4100 |
|
2 |
1 |
2 |
27 |
8.7 |
91 |
3 |
3 |
3 |
>1100 |
420 |
- |
|
注:如果接种量扩大10倍,分别为100.0 g,10.0 g和1 g时,表中的数字相应缩小10倍。如果接种量缩小10倍,分别为1.0 g,0.1 g和0.01 g时,表中的数字相应扩大10倍,其余类推。 |
|||||||||||
相关标准:
SN/T 2552.7-2010 乳与乳制品卫生微生物学检验方法 第7部分 阴沟肠杆菌检验 -标准下载
相关产品:
注:本文属海博生物原创,未经允许不得转载。
上一篇:柠檬酸杆菌的检验方法及结果判断



